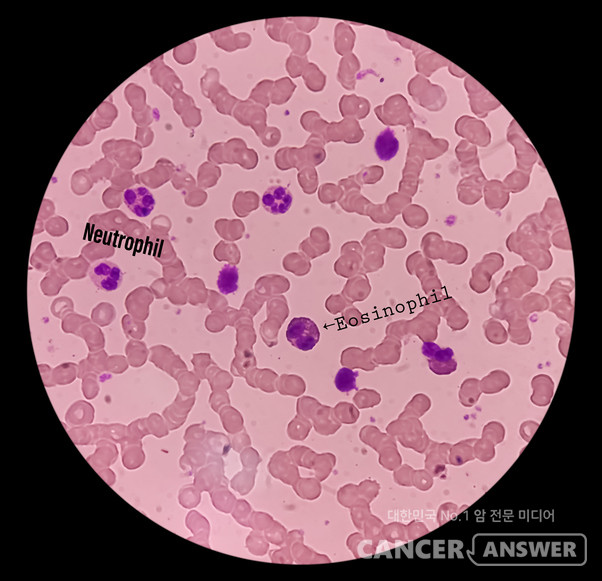
혈액검사를 하면 나오는 여러 항목의 수치 중에 암 치료 중인 환자가 가장 눈여겨봐야 할 항목 중 하나는 호중구다. 우리 혈액 구성 요소 중 하나인 백혈구는 과립구, 림프구, 대식세포로 나뉜다. 모두 면역 기능을 담당한다. 과립구의 95%가 호중구인데, 호중구는 감염 위험을 예측하고, 항암치료 일정에 영향을 미치며, 암 치료 중인 환자의 안전성과 예후를 가늠하는 핵심 요소로 사용된다. 왼쪽 Neutrophil 주변 보라색이 호중구./게티이미지뱅크

혈액검사를 하면 나오는 여러 항목의 수치 중에 암 치료 중인 환자가 가장 눈여겨봐야 할 항목 중 하나는 호중구다. 우리 혈액 구성 요소 중 하나인 백혈구는 과립구, 림프구, 대식세포로 나뉜다. 모두 면역 기능을 담당한다.
과립구의 95%가 호중구인데, 호중구는 감염 위험을 예측하고, 항암치료 일정에 영향을 미치며, 암 치료 중인 환자의 안전성과 예후를 가늠하는 핵심 요소로 사용된다.
<호중구는 무엇이고 어떤 역할을 하나>
호중구(Neutrophil)는 백혈구 중 가장 큰 비중을 차지하는 세포로, 세균 감염을 막는 1차 방어군이다. 폐렴균·대장균·황색포도상구균 등 세균을 탐지해 공격하며, 몸속 염증 반응을 주도한다.
<혈액검사지에서 호중구를 어떻게 찾나>
검사 결과지에 Neutrophil(%)이라는 항목이 있는데, 이것은 백혈구 중 호중구의 비율을 뜻한다. ANC(Absolute Neutrophil Count)는 절대호중구 수로, 혈액 1마이크로리터(μL)당 호중구의 수다. 검사 결과로 몸 상태를 파악하려고 할 때 절대호중구 수(ANC)에 유의하면 된다. 감염 위험도와 치료 방향을 주로 ANC를 기준으로 판단하기 때문이다.
<정상 단위와 호중구 범위>
성인의 정상 절대호중구 수는 1800~7000/μL이다. 혈액 1마이크로리터(100만분의1 리터) 당 호중구가 1800~7000개이면 정상이라는 뜻이다. 검사 결과 수치가 이 범위 안에 있으면 비교적 안정된 상태로 해석된다.
<호중구 증가증 vs 호중구 감소증>
절대호중구 수가 정상보다 높으면 ‘호중구 증가증’으로 부른다. 호중구 증가증, 즉 호중구가 정상보다 많은 것은 다음과 같은 원인 때문이다. ▷급성 세균 감염 ▷폐렴·충수염 같은 급성 염증 ▷조직 괴사(심근경색, 패혈증 등) ▷스테로이드 등 약물 영향 ▷스트레스·흡연 ▷종양·백혈병
호중구 수치가 정상보다 높은 상황이 지속적으로 계속되면 위 항목에 해당될 가능성이 있다. 호중구 증가증이 일시적이라면 걱정하지 않아도 된다.
절대호중구 수가 1500/μL 이하면 호중구 감소증으로 분류한다. 단계별 위험도는 다음과 같다.
▷경증: 1000~1500/μL → 감염 위험 약간 증가
▷중등도: 500~1000/μL → 감염 위험 뚜렷하게 증가
▷중증: <500/μL → 치명적 감염 위험 급증
중증 상태가 3개월 이상 지속되면 만성 호중구감소증으로 볼 수 있다. 원인은 항암제·방사선 치료, 바이러스 감염, 골수 기능 저하, 자가면역질환, 영양 결핍, 선천성 질환 등 다양하다.

<암치료 후 호중구가 급격히 떨어지면 어떤 문제가 생기나>
항암제 투여 후 7~14일 사이에 골수 기능이 억제되면서 호중구가 급격히 감소하는 시기를 ‘Nadir(나디르)’라고 한다. 이때 절대호중구 수가 500/μL 이하로 떨어지면 폐렴·요로감염·패혈증 등 감염 위험 급증이 급증한다. 심한 경우 생명을 위협하는 전신 감염이 발생한다.
이 상황이 되면 항암 치료 일정을 늦출 수밖에 없다. 항암제 용량을 줄이기도 한다. 감염 위험이 높기 때문에 타인과의 접촉을 최대한 피해야 한다. 최근 연구에 따르면 첫 항암 주기에 발열성 호중구감소증이 발생하면 전체 생존율(OS)도 낮아지는 경향이 보고되고 있다.
<발열 동반 호중구감소증(발열성 호중구감소증, FN)은 응급상황>
발열성 호중구감소증(FN)은 2023~2024 국제 가이드라인에서 ‘항암 환자에게 가장 위험한 응급 상황’으로 평가된다.
절대호중구 수가 500/μL 미만이고, 체온이 섭씨 38도 이상으로 1시간 이상 지속되면 2시간 이내에 응급실에 가야 한다. 지연되면 패혈증으로 빠르게 악화될 수 있기 때문이다.
<<호중구가 정상 범위를 벗어났을 때 암 환자의 대처 방법>
ANC 1000~1500 : ▷감염원 노출 최소화 ▷충분한 수면·수분 섭취 ▷상처 관리·손 씻기 철저
ANC 500~1000 : ▷생야채·생선회·김치 등 가열되지 않은 음식 금지 ▷대중 밀집 시설 방문 제한 ▷병원 방문 시 KF94 마스크 필수 ▷면역억제제 병행 시 각별한 관리 필요
ANC <500 : ▷고위험 단계 ▷가벼운 미열이라도 즉시 의료진에 연락 ▷필요 시 G-CSF(호중구 증가 촉진제) 투여 ▷감염 의심 시 예방적 항생제 고려
38도 이상의 발열 : ▷지체 없이 병원 내원(2시간 이내) ▷패혈증 위험이 높아 응급 진료 필요 ▷가정에서 해열제 단독 복용 금지

